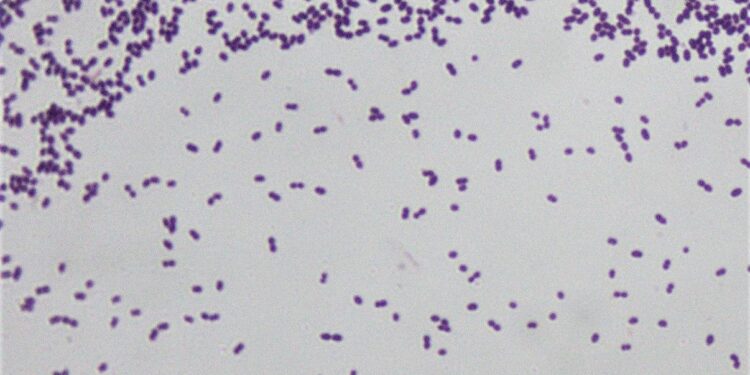

In a groundbreaking study published in Nature, researchers are shining a spotlight on Enterococcus faecalis, a notorious bacterium frequently implicated in dental root canal infections. Traditionally viewed through a narrow lens as mere pathogens, E. faecalis and its polymicrobial companions are now being recognized for their complex ecological roles within the oral microbiome. This new perspective challenges existing paradigms, suggesting that these microbes may not only contribute to disease but also interact dynamically with their environment, potentially influencing treatment outcomes. As dental professionals grapple with persistent infections resistant to conventional therapies, understanding the intricate relationships among these microorganisms could lead to innovative strategies for effective management and prevention. In this article, we delve into the findings that paint a more nuanced picture of E. faecalis and the broader implications for dental health.
Understanding the Role of Enterococcus faecalis in Root Canal Infections
The presence of Enterococcus faecalis in root canal infections has long been a topic of research and discussion within the dental community. This bacterium is notable not just for its resilience but also for its role as a key player in the polymicrobial environment of endodontic infections. Studies indicate that E. faecalis can survive the rigorous conditions encountered during endodontic treatment, often becoming the dominant organism in persistent infections. Its ability to form biofilms enhances its resistance to both conventional treatments and the host’s immune response, complicating the healing process and necessitating a deeper understanding of its ecological interactions.
Moreover, E. faecalis does not operate in isolation; rather, it interacts with a myriad of other microorganisms within the root canal. This polymicrobial community might include bacteria such as Fusobacterium, Prevotella, and various species of Enterobacteriaceae, each contributing to the pathogenicity of the infection. The interplay among these species can lead to a synergistic effect, enhancing virulence and resistance against therapeutic interventions. Understanding these relationships is crucial for developing effective strategies that address not only E. faecalis but also the broader microbial consortium involved in root canal infections.
Exploring the Impact of Polymicrobial Interactions on Dental Health
The intricate dynamics of polymicrobial interactions significantly influence dental health, particularly in the context of root canal infections. Recent studies shed light on the role of Enterococcus faecalis, a notable bacterium frequently isolated from infected root canals. Its survival strategies and the ability to form biofilms contribute to the challenges faced in endodontic treatments. The adaptability of E. faecalis allows it to thrive in diverse environments, often leading to persistent infections. Understanding these microbial communities paves the way for developing more targeted therapies aimed at disrupting these complex interactions.
Key factors regarding the ecological role of E. faecalis in dental infections include:
- Biofilm Formation: E. faecalis possesses a remarkable capacity to form biofilms, shielded from antibiotic action and the host’s immune response.
- Cross-Interactivity: This bacterium interacts with numerous other microbial species, potentially influencing their virulence and resistance profiles.
- Metabolic Cooperation: E. faecalis may engage in metabolic exchanges with adjacent bacteria, bolstering survival rates for the entire polymicrobial community.
To illustrate the relevance of these interactions, the following table summarizes the characteristics of E. faecalis compared to other dominant bacteria found in root canal infections:
| Bacteria | Biofilm Formation | Antibiotic Resistance | Role in Infection |
|---|---|---|---|
| Enterococcus faecalis | High | Significant | Persistent infections |
| Streptococcus spp. | Moderate | Moderate | Initial colonization |
| Prevotella spp. | Low | Low | Pathogen synergy |
Strategies for Managing Enterococcus faecalis in Endodontic Treatments
To effectively manage Enterococcus faecalis in endodontic treatments, practitioners are increasingly adopting a range of targeted strategies. Firstly, incorporating antimicrobial agents into the root canal disinfection protocol is essential. Agents such as chlorhexidine digluconate and calcium hydroxide have shown promising results in significantly reducing E. faecalis colonies. Additionally, utilizing bioactive materials can enhance the healing process and minimize reinfection. For instance, products containing mineral trioxide aggregate (MTA) can provide an effective barrier against microbial invasion and support pulp healing.
Furthermore, the role of irrigation techniques cannot be overstated in controlling E. faecalis. Employing a combination of mechanical and chemical methods may yield the best outcomes. Among these, the use of ultrasonic activation has been demonstrated to enhance the efficacy of irrigants, ensuring deeper penetration into the dentinal tubules. Moreover, therapeutic protocols that incorporate re-evaluation of the microbial load post-treatment can assist in monitoring the treatment efficacy. Keeping abreast of emerging studies is crucial, considering the polymicrobial nature of endodontic infections, which necessitates a comprehensive approach to managing E. faecalis and its interactions within the root canal ecosystem.
In Retrospect
the research into Enterococcus faecalis provides valuable insights into its multifaceted role within the complicated ecosystem of dental root canal infections. As scientists continue to explore the polymicrobial nature of oral diseases, understanding the interactions between E. faecalis and other microbial species will be critical for developing more effective treatment strategies. This emerging perspective not only highlights the need for a holistic approach to dental health but also calls for further investigation into the intricate relationships that shape our oral microbiome. As we advance our knowledge in this field, the hope is to improve patient outcomes and transform the way we tackle dental infections in the future. Stay tuned for further developments as the scientific community delves deeper into the complexities of oral microbiology.